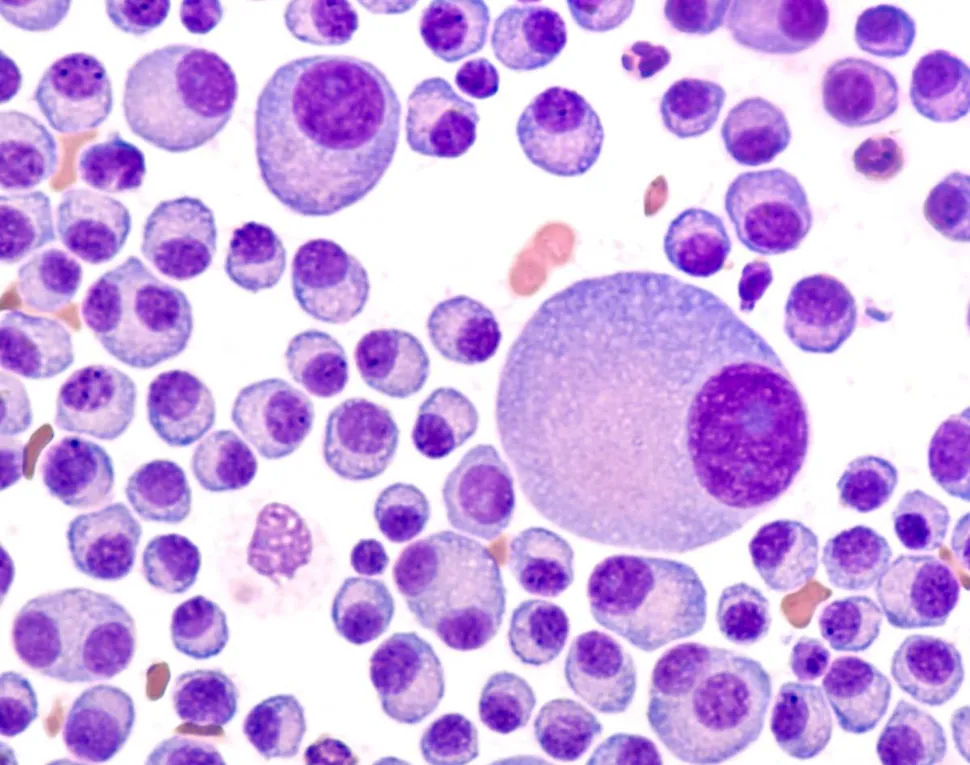
What Is Multiple Myeloma and Where Can I Find Help? image

What Is Multiple Myeloma and Where Can I Find Help?
March is Multiple Myeloma Awareness Month and there is significant help and support available for myeloma patients.
What is Multiple Myeloma?
Multiple myeloma is a blood cancer of plasma cells, a type of white blood cell that normally fights infections. Myeloma occurs when one of these early B cells becomes genetically mutated and then replicates quickly, crowding out normal cells. Because these myeloma cells multiply at a faster rate than normal cells and don't die when they should, one antibody will grow out of control and eventually crowd out other plasma cells.
If not treated, the myeloma cells can:
- crowd out functioning white cells, and the immune system can’t guard against infection effectively
- secrete high levels of protein in the blood and urine, which can lead to kidney damage
- build up in bone, causing it to weaken, which can lead to bone pain and fractures
Common Symptoms of Multiple Myeloma
- Bone problems or bone breakages from a minor stress or injury
- Low blood counts which can cause anemia
- High blood calcium can cause frequent thirst, the need to drink a lot of fluids, and frequent urination. It can also cause dehydration and even kidney failure. High calcium can also cause severe constipation and loss of appetite.
- Bone destruction can cause weakness in the spine. If bones collapse, they can cause severe pain, numbness, and/or muscle weakness.
- Kidney problems caused by the myeloma protein
- Frequent infections. Myeloma patients are about 15 times more likely to get infections and may stay sick for longer period of time. Pneumonia is a common and serious infection.
Where To Find Myeloma Help
You can find help to navigate your multiple myeloma with support from the Myeloma Crowd by HealthTree. This includes help through a variety of ways and programs:
- MyelomaCrowd.org - myeloma news in patient-friendly terms
- Myeloma Specialist Directory - because you need a MM specialist on your care team
- Myeloma Coach - experienced patients or caregivers who provide on-one-one support
- HealthTree University - the only comprehensive curriculum taught by 100 MM experts with over 360 classes
- HealthTree Cure Hub - a myeloma patient portal of over 10,000 patients that helps patients navigate their myeloma while also contributing to research
- Myeloma Crowd Radio - podcasts with multiple myeloma experts
- Myeloma Crowd Round Tables - live meetings with myeloma experts
- Myeloma Crowd Community - topic based and geographic chapters with monthly webinars
What is Multiple Myeloma? (On HealthTree University)
Call Us
If you need help navigating your multiple myeloma, please call us at 1-800-709-1113. We have a team of Patient Navigators that can answer your questions and direct you to the correct resources.
March is Multiple Myeloma Awareness Month and there is significant help and support available for myeloma patients.
What is Multiple Myeloma?
Multiple myeloma is a blood cancer of plasma cells, a type of white blood cell that normally fights infections. Myeloma occurs when one of these early B cells becomes genetically mutated and then replicates quickly, crowding out normal cells. Because these myeloma cells multiply at a faster rate than normal cells and don't die when they should, one antibody will grow out of control and eventually crowd out other plasma cells.
If not treated, the myeloma cells can:
- crowd out functioning white cells, and the immune system can’t guard against infection effectively
- secrete high levels of protein in the blood and urine, which can lead to kidney damage
- build up in bone, causing it to weaken, which can lead to bone pain and fractures
Common Symptoms of Multiple Myeloma
- Bone problems or bone breakages from a minor stress or injury
- Low blood counts which can cause anemia
- High blood calcium can cause frequent thirst, the need to drink a lot of fluids, and frequent urination. It can also cause dehydration and even kidney failure. High calcium can also cause severe constipation and loss of appetite.
- Bone destruction can cause weakness in the spine. If bones collapse, they can cause severe pain, numbness, and/or muscle weakness.
- Kidney problems caused by the myeloma protein
- Frequent infections. Myeloma patients are about 15 times more likely to get infections and may stay sick for longer period of time. Pneumonia is a common and serious infection.
Where To Find Myeloma Help
You can find help to navigate your multiple myeloma with support from the Myeloma Crowd by HealthTree. This includes help through a variety of ways and programs:
- MyelomaCrowd.org - myeloma news in patient-friendly terms
- Myeloma Specialist Directory - because you need a MM specialist on your care team
- Myeloma Coach - experienced patients or caregivers who provide on-one-one support
- HealthTree University - the only comprehensive curriculum taught by 100 MM experts with over 360 classes
- HealthTree Cure Hub - a myeloma patient portal of over 10,000 patients that helps patients navigate their myeloma while also contributing to research
- Myeloma Crowd Radio - podcasts with multiple myeloma experts
- Myeloma Crowd Round Tables - live meetings with myeloma experts
- Myeloma Crowd Community - topic based and geographic chapters with monthly webinars
What is Multiple Myeloma? (On HealthTree University)
Call Us
If you need help navigating your multiple myeloma, please call us at 1-800-709-1113. We have a team of Patient Navigators that can answer your questions and direct you to the correct resources.
about the author
Jennifer Ahlstrom
Myeloma survivor, patient advocate, wife, mom of 6. Believer that patients can contribute to cures by joining HealthTree Cure Hub and joining clinical research. Founder and CEO of HealthTree Foundation.
More on Navigating Your Health
Trending Articles
Upcoming Events




Get the Latest Multiple Myeloma Updates, Delivered to You.
By subscribing to the HealthTree newsletter, you'll receive the latest research, treatment updates, and expert insights to help you navigate your health.
Together we care.
Together we cure.
3x Faster.









